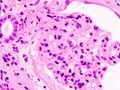
تصغير للنسخة بتاريخ 00:37، 9 أكتوبر 2009

ملف:Nodular glomerulosclerosis.jpeg
Nodular_glomerulosclerosis.jpeg (700 × 479 بكسل حجم الملف: 84 كيلوبايت، نوع MIME: image/jpeg)
تاريخ الملف
اضغط على زمن/تاريخ لرؤية الملف كما بدا في هذا الزمن.
| زمن/تاريخ | صورة مصغرة | الأبعاد | مستخدم | تعليق | |
|---|---|---|---|---|---|
| حالي | ★ مراجعة معتمدة 00:39، 9 أكتوبر 2009 |  | 700 × 479 (84 كيلوبايت) | Khalil111 (نقاش | مساهمات) | |
| 00:37، 9 أكتوبر 2009 | | 700 × 527 (68 كيلوبايت) | Khalil111 (نقاش | مساهمات) | ||
| 00:35، 9 أكتوبر 2009 |  | 700 × 479 (84 كيلوبايت) | Khalil111 (نقاش | مساهمات) |
لا يمكنك استبدال هذا الملف.
وصلات
الصفحات التالية تحتوي على وصلة لهذه الصورة:
